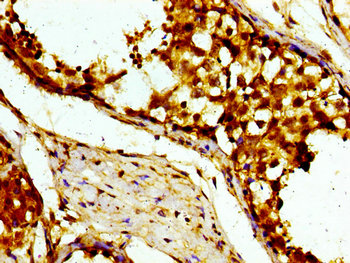

USP10 Antibody
-
中文名稱:USP10兔多克隆抗體
-
貨號(hào):CSB-PA613516LA01HU
-
規(guī)格:¥440
-
圖片:
-
Western Blot
Positive WB detected in: Hela whole cell lysate, 293 whole cell lysate, A549 whole cell lysate, Rat liver tissue
All lanes: USP10 antibody at 3μg/ml
Secondary
Goat polyclonal to rabbit IgG at 1/50000 dilution
Predicted band size: 88, 93 kDa
Observed band size: 88 kDa -
Immunohistochemistry of paraffin-embedded human testis tissue using CSB-PA613516LA01HU at dilution of 1:100
-
Immunofluorescent analysis of Hela cells using CSB-PA613516LA01HU at dilution of 1:100 and Alexa Fluor 488-congugated AffiniPure Goat Anti-Rabbit IgG(H+L)
-
Immunoprecipitating USP10 in A549 whole cell lysate
Lane 1: Rabbit control IgG instead of CSB-PA613516LA01HU in A549 whole cell lysate. For western blotting, a HRP-conjugated Protein G antibody was used as the secondary antibody (1/2000)
Lane 2: CSB-PA613516LA01HU (8μg) + A549 whole cell lysate (500μg)
Lane 3: A549 whole cell lysate (10μg)
-
-
其他:
產(chǎn)品詳情
-
產(chǎn)品名稱:Rabbit anti-Homo sapiens (Human) USP10 Polyclonal antibody
-
Uniprot No.:
-
基因名:
-
別名:Deubiquitinating enzyme 10 antibody; KIAA0190 antibody; MGC124997 antibody; MGC2621 antibody; Ubiquitin carboxyl terminal hydrolase 10 antibody; Ubiquitin carboxyl-terminal hydrolase 10 antibody; Ubiquitin specific peptidase 10 antibody; Ubiquitin specific processing protease 10 antibody; Ubiquitin specific protease 10 antibody; Ubiquitin thioesterase 10 antibody; Ubiquitin thiolesterase 10 antibody; Ubiquitin-specific-processing protease 10 antibody; UBP10_HUMAN antibody; UBPO antibody; USP 10 antibody; USP10 antibody
-
宿主:Rabbit
-
反應(yīng)種屬:Human, Rat
-
免疫原:Recombinant Human Ubiquitin carboxyl-terminal hydrolase 10 protein (453-592AA)
-
免疫原種屬:Homo sapiens (Human)
-
標(biāo)記方式:Non-conjugated
本頁(yè)面中的產(chǎn)品,USP10 Antibody (CSB-PA613516LA01HU),的標(biāo)記方式是Non-conjugated。對(duì)于USP10 Antibody,我們還提供其他標(biāo)記。見下表:
-
克隆類型:Polyclonal
-
抗體亞型:IgG
-
純化方式:>95%, Protein G purified
-
濃度:It differs from different batches. Please contact us to confirm it.
-
保存緩沖液:Preservative: 0.03% Proclin 300
Constituents: 50% Glycerol, 0.01M PBS, pH 7.4 -
產(chǎn)品提供形式:Liquid
-
應(yīng)用范圍:ELISA, WB, IHC, IF, IP
-
推薦稀釋比:
Application Recommended Dilution WB 1:500-1:5000 IHC 1:20-1:200 IF 1:50-1:200 IP 1:200-1:2000 -
Protocols:
-
儲(chǔ)存條件:Upon receipt, store at -20°C or -80°C. Avoid repeated freeze.
-
貨期:Basically, we can dispatch the products out in 1-3 working days after receiving your orders. Delivery time maybe differs from different purchasing way or location, please kindly consult your local distributors for specific delivery time.
-
用途:For Research Use Only. Not for use in diagnostic or therapeutic procedures.
相關(guān)產(chǎn)品
靶點(diǎn)詳情
-
功能:Hydrolase that can remove conjugated ubiquitin from target proteins such as p53/TP53, BECN1, SNX3 and CFTR. Acts as an essential regulator of p53/TP53 stability: in unstressed cells, specifically deubiquitinates p53/TP53 in the cytoplasm, leading to counteract MDM2 action and stabilize p53/TP53. Following DNA damage, translocates to the nucleus and deubiquitinates p53/TP53, leading to regulate the p53/TP53-dependent DNA damage response. Component of a regulatory loop that controls autophagy and p53/TP53 levels: mediates deubiquitination of BECN1, a key regulator of autophagy, leading to stabilize the PIK3C3/VPS34-containing complexes. In turn, PIK3C3/VPS34-containing complexes regulate USP10 stability, suggesting the existence of a regulatory system by which PIK3C3/VPS34-containing complexes regulate p53/TP53 protein levels via USP10 and USP13. Does not deubiquitinate MDM2. Deubiquitinates CFTR in early endosomes, enhancing its endocytic recycling. Involved in a TANK-dependent negative feedback response to attenuate NF-kappaB activation via deubiquitinating IKBKG or TRAF6 in response to interleukin-1-beta (IL1B) stimulation or upon DNA damage. Deubiquitinates TBX21 leading to its stabilization.
-
基因功能參考文獻(xiàn):
- By using a genome wide siRNA screen for deubiquitinating enzymes, we identified USP10 as a deubiquitinase for Slug in cancer cells. USP10 interacts with Slug and mediates its degradation by the proteasome. Importantly, USP10 is concomitantly highly expressed with Slug in cancer biopsies. PMID: 29803676
- Loss of USP10 expression is associated with small intestinal adenocarcinoma. PMID: 30375264
- One of the USP10 targets is TP53. Wildtype TP53 is usually rescued from proteasomal degradation by USP10. As most KMT2A leukemias display wildtype p53 alleles, one might argue that the disruption of an USP10 allele can be classified as a pro-oncogenic event. PMID: 30107050
- Deubiquitylase USP10 interacts with RNF168 and TOP2alpha, and restrains ubiquitylation of TOP2alpha as well as its chromatin binding. PMID: 27558965
- USP10 directly interacted with and stabilized PTEN via deubiquitination. PMID: 28852924
- A controlling role for USP10 after wounding in determining myofibroblast development and activation of fibrotic TGFbeta signaling. PMID: 28851806
- Investigate the expression of USP10 in the human normal adrenal gland and various adrenal tumors. In adrenal tumors, detectable levels of USP10 protein were found in 100 % (30/30) adrenocortical adenomas, 88.89 % (8/9) adrenocortical carcinomas, and 10 % (2/20) pheochromocytomas. PMID: 26555087
- G3BP mediates the condensation of stress granules by shifting between two different states that are controlled by the phosphorylation of S149 and by binding to Caprin1 or USP10. PMID: 27022092
- Data demonstrated that AMPK-USP10 form a positive feedforward loop that ensures amplification of AMPK activation in response to fluctuation of cellular energy status. PMID: 26876938
- miR-191 could promote pancreatic cancer progression through targeting USP10, implicating a novel mechanism for the tumorigenesis. PMID: 25168367
- USP10 deubiquitinates and stabilizes SIRT6. PMID: 24332849
- this study identified USP10, a carboxyl-terminal ubiquitin-processing protease, could interact with T-bet in the nucleus. PMID: 24845384
- USP10 is a host factor that inhibits stress-induced reactive oxygen species production and apoptosis in HTLV-1-infected T cells. PMID: 23775713
- a novel function for USP10 in facilitating the deubiquitination of CFTR in early endosomes, thereby enhancing the endocytic recycling and cell surface expression of CFTR. PMID: 20215869
- Findings reveal USP10 to be a novel regulator of p53, providing an alternative mechanism of p53 inhibition in cancers with wild-type p53. PMID: 20096447
- The data indicate that USP10 is a new cofactor that binds to the androgen receptor (AR) and stimulates the androgen response of target promoters. This finding underlines the role of the ubiquitin/proteasome system in modulating the AR function. PMID: 16368182
- RTQ-LDA and RTQ identified ubiquitin specific protease 10 as significantly over-expressed in dead-of-disease compared to long-term survival glioblastoma multiforme patients. PMID: 16773218
- USP10 has a role in facilitating the deubiquitination of CFTR in early endosomes and thereby enhancing the endocytic recycling of CFTR PMID: 19398555
- Ras-GAP SH3 domain binding protein (G3BP) is a modulator of USP10. G3BP does not appear to be a substrate of USP10; it rather inhibits its ability to disassemble ubiquitin chains. PMID: 11439350
顯示更多
收起更多
-
亞細(xì)胞定位:Cytoplasm. Nucleus. Early endosome.
-
蛋白家族:Peptidase C19 family, USP10 subfamily
-
組織特異性:Widely expressed.
-
數(shù)據(jù)庫(kù)鏈接:
Most popular with customers
-
-
YWHAB Recombinant Monoclonal Antibody
Applications: ELISA, WB, IHC, IF, FC
Species Reactivity: Human, Mouse, Rat
-
-
-
-
-
-